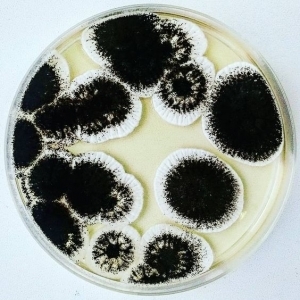
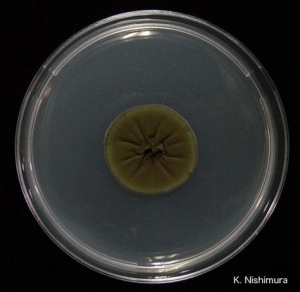

El moho es un agente silencioso que se cuela en casa sin que te des cuenta. Poco a poco comienza a afectar tu salud y las paredes o estructuras de tu hogar. Sin embargo, nunca es tarde para tratar el problema.
Después de una larga investigación, te he preparado un artículo con todo lo que debes saber de este hongo. Además, te contaré algunos consejos que puedes poner en práctica para prevenir su aparición o eliminarlo.
¿Qué es el moho?
El moho es un organismo microscópico que ayuda a reciclar los nutrientes que están en el medioambiente y a descomponer la materia muerta.
Además, puedes encontrar los diferentes tipos de este hongo en cualquier parte del mundo. Porque crecen con facilidad en lugares donde tengan acceso a residuos animales o vegetales.
¿Cómo se reproduce el moho en el hogar?
Lo primero que debes conocer es que las esporas del hongo son partículas muy pequeñas y ligeras que se trasladan por el aire sin problemas.
Es decir que el moho puede entrar en tu hogar a través de una ventana abierta, el sistema del aire acondicionado, en las patas de tu mascota, pegado a tu ropa, entre otros.
En pocas palabras, no puedes evitar que el organismo multicelular entre en tu casa.
Sin embargo, para que el moho se reproduzca necesita estar en un lugar con altos niveles de humedad (paredes o techos con filtraciones, tuberías rotas, macetas con exceso de agua, materiales de construcción de celulosa húmedos, paneles de yeso, alfombras…)
De no existir las condiciones apropiadas para su reproducción, el organismo muere con el paso de los días.
Tipos de moho
Este hongo tiene una amplia variedad de especies que crecen tanto al aire libre como dentro de tu hogar. Los más comunes que puedes encontrar en el interior y exterior de las edificaciones son:
Moho rosa
El Serratia marcescens es una especie que aparece con frecuencia en las duchas, el inodoro y entre las juntas de las cerámicas o los azulejos. Ya que para crecer necesita estar en un lugar con altos niveles de humedad sostenida.

Además, es muy fácil de detectar porque al reproducirse el área afectada adquiere una tonalidad rosa claro.
Los estudios sugieren que este hongo no tiene un alto nivel de toxicidad, pero sí puede provocar infecciones en el tracto urinario (debido a donde crece).
Moho blanco
La Sclerotina sclerotiorum solo necesita estar en contacto con bajas concentraciones de humedad para reproducirse.
Este hongo puede resultar complicado de eliminar, ya que no notarás su presencia hasta que se haya extendido por la superficie. Y cuando aparece se asemeja a una capa de polvo blanco con una textura similar a la del algodón.

Según Puro Clean (empresa de limpieza de organismos de riesgos biológicos), una vez que detectas este tipo de moho es importante que lo quites de manera inmediata, porque provoca diferentes problemas en las construcciones y también de salud.
Los síntomas más comunes causados por este hongo son: reacciones alérgicas, episodios de dolor de cabeza prolongados, irritación ocular, mareos, náuseas, etc.
Moho negro
El Stachybotrys chartarum es una de las 60 especies de moho negro que puedes encontrar en casa y el organismo más tóxico.
Se caracteriza por ser de color negruzco y verdoso, con una apariencia viscosa debido a que la humedad se concentra en la capa superior del organismo.

Además, a pesar de que desaparezca el vapor de agua que le permite reproducirse, y se seque, el moho no deja de generar partículas nocivas para tu salud.
Este organismo es capaz de producir diferentes complicaciones médicas como: infecciones en la piel (incluso sin estar en contacto directo), irritación de las mucosas, problemas respiratorios, entre otros.
Por otra parte, ten presente que este hongo crece en lugares escondidos donde existe una filtración de agua. Así que te sugiero revisar de manera periódica los espacios que sepas que tienen ese problema.
Moho Aspergillus
Este hongo es más propenso a crecer cerca de zonas en construcción o áreas con acceso a gran cantidad de abono. Ya que, este moho se desarrolla con facilidad en espacios con materia orgánica (como macetas).
A diferencia del tipo anterior, la tonalidad del moho es negra y no tiene otros colores.
Ahora bien, el organismo se origina a través de compuestos venenosos, por lo que si inhalas o estás en contacto con sus esporas es posible que enfermes en poco tiempo.
Según Cleveland Clinic las complicaciones generadas por este moho son: tos acompañada de mucosa o sangre, dificultad para respirar, fiebre, dolores en el pecho, episodios de asma al realizar ejercicio, fallos en los riñones o el hígado, etc.
Moho Alternaria
Este organismo se caracteriza por aparecer en lugares húmedos y oscuros, por ejemplo, debajo del fregadero de tu cocina. No obstante, existen estudios que han descubierto este tipo de moho también en lugares con poca concentración de vapor de agua.

Cuando aparece por primera vez lo puedes distinguir como unas manchas oscuras en la pared, pero con el paso del tiempo es capaz de pudrir cualquier tejido, plantas o paneles de yeso que estén cerca del organismo.
Quirón salud expone que la principal desventaja de este moho es que produce problemas respiratorios graves en personas con un sistema inmunológico vulnerable (niños, ancianos y enfermos).
Moho Penicillium
Según National Geographic, este organismo es la base para la creación de la penicilina, un medicamento muy conocido en el área de la medicina.
Sin embargo, esto no significa que sea inofensivo. IQAIR explica que al estar en contacto con las esporas del hongo tu salud puede verse afectada con alergias crónicas o inflamación pulmonar.

Este tipo de moho se caracteriza por ser de color azul y verde al reproducirse. Y puedes encontrarlo en objetos antiguos y aislados por mucho tiempo (muebles o libros) o en algunas de tus comidas (queso, pan, frutas).
Además, es importante que sepas que este organismo se esparce con mucha facilidad, solo necesitas mover un objeto contaminado para que las esporas viajen en el ambiente.
Moho Cladosporium
Las maderas viejas, el cuero, plástico y papel expuesto a la humedad es el lugar ideal de reproducción del Cladosporium.
Asimismo, el hongo tiene un color característico (verde oliva y marrón) que te permite distinguirlo con facilidad de otra cepa.
Según IQAIR al estar en contacto con este hongo puedes presentar problemas respiratorios: tos y secreción nasal.
Moho Mucor
¿Alguna vez te has olvidado de un trozo de pan y después te das cuenta de que tiene una capa de moho cubriéndolo? El Mucor es el organismo responsable de eliminar los restos de alimentos podridos, ya sea dentro de tu hogar, como en el exterior. Pero también puedes encontrarlo encima de plantas o paredes.

Durante su reproducción el hongo suele pasar por diferentes tonalidades como: beige, marrón, blanco y gris.
No obstante, a pesar de su función (de descomposición de desechos) el moho es tóxico para el ser humano. Y el Manual MDS señala que es capaz de producir infecciones fúngicas en diferentes partes de tu cuerpo, que provocan fiebre, tos y dificultad respiratoria.
Moho Sporotrichum
Es muy poco probable que encuentres este organismo dentro de tu casa, ya que su lugar ideal de crecimiento es el jardín. No importa si tus plantas están vivas o muertas, el moho crece hasta consumirlas por completo.

Al inicio el hongo aparece como pequeños puntos blancos, pero con el tiempo se convierte en una membrana grisácea.
Según el Manual MDS si tus manos (o cualquier zona de tu piel) entra en contacto con el organismo corres el riesgo de padecer una micosis subcutánea o una reacción alérgica.
Moho Neurospora
Este es el hongo que aparece en tus panes cuando estos ya están viejos. Al principio puedes verlo formarse con un color rosado, pero a medida que crece su tono cambia a verde.

Si tienes algún alimento con la presencia de este organismo, te sugiero que lo deseches de inmediato.
Medline Plus expone que si lo comes (incluso si quitas la zona afectada) es posible que desarrolles una enfermedad en el tracto digestivo, que puede durar varios días.
¿Cómo quitar el moho de tu casa?
Sé que todo lo que te he contado sobre estos organismos puede causarte miedo, pero no tienes que preocuparte. A pesar de todos los efectos negativos, este virus es fácil de eliminar de tu hogar.
Para ello tienes que seguir los siguientes pasos:
- Localiza el espacio contaminado con el hongo.
- Limpia y desinfecta (con una mezcla de 1 ½ de lejía o vinagre blanco por cada 3,8 litros de agua) el área. Después quita el exceso de humedad y deja secar el lugar de manera natural durante 24 horas.
- Embolsa y tira cualquier material que tenga moho, aunque sea poco. Por ejemplo: papel, comida, hojas, basura, etc.
- Si es posible, evita que vuelva a acumularse la humedad.
Recuerda que todo este proceso tienes que hacerlo con guantes, mascarilla (de preferencia N95 o TC-21C) y ropa que proteja la superficie de tu piel. Esta medida te ayuda a evitar que las esporas estén en contacto con tu cuerpo.
Además, te sugiero bañarte cuando termines de limpiar para eliminar restos de moho en tu cuerpo. De esta forma evitarás reacciones alérgicas en tu piel.
Consejos para mantener el moho fuera de tu hogar
Aunque no lo parezca, es muy fácil prevenir la aparición de cualquier tipo de hongo en tu casa. Para ello te aconsejo hacer lo siguiente:
- Utiliza un deshumidificador que elimine la concentración de vapor de agua en tus habitaciones.
- Ventila de manera adecuada los espacios de lavandería, cocina y baños.
- Repara las filtraciones que tengas en casa.
- Después de una inundación, asegúrate de secar por completo el espacio afectado.
- Evita el uso de alfombras en el cuarto de baño.
Te he preparado una guía que te ayudará a decidir si necesitas comprar un deshumidificador para casa

Preguntas frecuentes sobre el moho
Ya te he contado todo lo que debes saber respecto a este hongo, pero estoy segura de que aún tienes muchas dudas. Así que he preparado para ti una pequeña lista de las preguntas más comunes que suelen surgir respecto a la aparición del moho.
¿Qué probabilidad hay de que aparezca el moho en casa?
Es muy frecuente que cualquier tipo de este hongo se reproduzca en tu hogar. Ya que viajan con facilidad en el ambiente y solo necesitan un pequeño espacio con humedad para crecer y extenderse por todo tu hogar.
No obstante, no existe ningún estudio que concrete la frecuencia con la que es posible encontrar el hongo en una casa o edificación.
¿A qué huele el moho?
El olor de este organismo multicelular aparece mucho antes de que puedas verlo en tus paredes. Así que, si comienzas a detectar un aroma a humedad o un hedor rancio, te sugiero revisar tu hogar.
Recuerda que puedes tratar el problema por ti mismo o contratar a un profesional que se haga cargo.
¿Qué prueba debo hacer para saber qué tipo de moho tengo en casa?
Según el Centro para el Control y la Prevención de Enfermedades (CDC) una vez que veas o huelas el hongo, debes eliminarlo de manera instantánea. Ya que, mientras tomas una muestra y la analizas, el organismo sigue produciendo partículas nocivas que afectan tu salud y la de tus seres queridos.
Así que, sin importar que tipo de moho sea, debes tomar las medidas adecuadas para quitarlo por completo de tu hogar.

¿Quiénes tienen mayor riesgo de presentar problemas de salud por el moho?
Las personas más susceptibles al estar en contacto con las esporas del organismo son aquellas que:
- Tienen un sistema inmunológico vulnerable.
- Padecen problemas respiratorios o enfermedades pulmonares.
- Personas con VIH.
¿Debería preocuparme por encontrar moho en mi casa?
Sí, cuando la contaminación es excesiva. Recuerda que el hongo no solo afectará a tu salud, sino también produce un daño estructural en tu casa (puede ocasionar torceduras en la madera y paredes agrietadas, entre otros). Así que es importante tratar el problema en el momento que lo descubras.
Encontré moho en casa, ¿debería irme mientras lo quitan?
Esta decisión depende solo de ti. Si crees que estás enfermo por la exposición al hongo puedes salir de tu casa mientras se resuelve el problema. No obstante, te sugiero consultar con un médico para saber qué medidas debes tomar en este caso.
Conclusión
Como ves, la característica en común que tienen todos estos hongos es que necesitan de la humedad para reproducirse en tu hogar. Pero recuerda que los deshumidificadores son excelentes aliados para disminuir el riesgo de la aparición del moho en tu casa.



